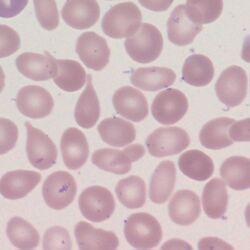

Teardrop cells
From haematologyetc.co.uk
Derivation: Descriptive plus Greek poikilos [varied]
Appearance
The abnormal cells have the shape of a tear drop.
Imaages: Sometimes described as having a “pinched top”, but the resemblance to a tear drop is probably the best description. Note that most often the cell is otherwise a normal erythrocyte with central pallor generally retained; but that other abnormal features (e.g. basophilic stippling, crenation, hypochromia) may all also occur. Features of infiltration or marrow hyperplasia may also be seen e.g. polychromasia, circulating nucleated red cells.
Significance
The tear drop appearance is strongly indicative of a “packed marrow”. This may be the result of infiltration by a disease process: e.g. fibrosis (primary or secondary) or neoplasm (carcinoma or haematological neoplasm). However, these cells may also arise where there is sustained or severe physiological increase in blood cell production (e.g. the expanded erythroid response to thalassaemia) may also case these cells to be produced. Other features suggesting infiltration or disease will generally be present, as may features suggesting a specific cause. Less frequent tear drop forms may arise in other systemic disease (see causes).
Pitfalls
Tear drop cells have a distinctive appearance and so while they may superficially resemble elliptocytes or ovalocytes, the are not usually confused with other cell types. The major point of importance is to make a careful examination of other cells that may provide clues as to why tear drop forms are present.
Causes
| Intrinsic bone marrow disease |
|---|
| Primary myelofibrosis: often associated with prominent of frequent forms – look for other features of infiltration and characteristic changes to other blood cells. |
| Secondary marrow fibrosis (including carcinoma and TB; rarely congenital conditions) |
| Haematological malignancy – abnormal white cells will generally be present. |
| Packed or extramedullary red cell formation |
| Predominantly thalassaemia, but also may occur in a range of haemoglobinopathies |
| Particular dyserythropoietic disease states |
| Megaloblastic anaemia and myelodysplasia |
Clinical Examples
Clinical Image 1: Very frequent tear drop forms (including a very small one – centre overlying other cells). This is caused by myelofibrosis. The diagnosis cannot be made from this small field, but note very high frequency of tear drop forms that my be typical of this condition. Clinical condition: myelofibrosis
Clinical Image 2: Poorly-formed but recognisable tear drop cell amongst many abnormal erythrocytes and hypogranular platelets. Note also the bi-lobed (pseudo-Pelger) neutrophil. This is myelodysplasia with occasional tear drop cells. Clinical condition: myelodysplasia
Clinical Image 3: A single well-formed tear drop cell. However, in this case there is also a primitive (blast) cell and a basophil present. Platelets also appear greatly increased. In this case the condition is again myelofibrosis although in this case the circulating blast cell should raise concern about possible transformation. Clinical condition: myelofibrosis
Pathobiology
The precise mechanism by which tear drop cells are formed is unclear; there is a view that the cells represent the result of erythropoiesis occurring outside the normal marrow adhesive environment, although the “pitting function” of the spleen may also play a role in their formation.